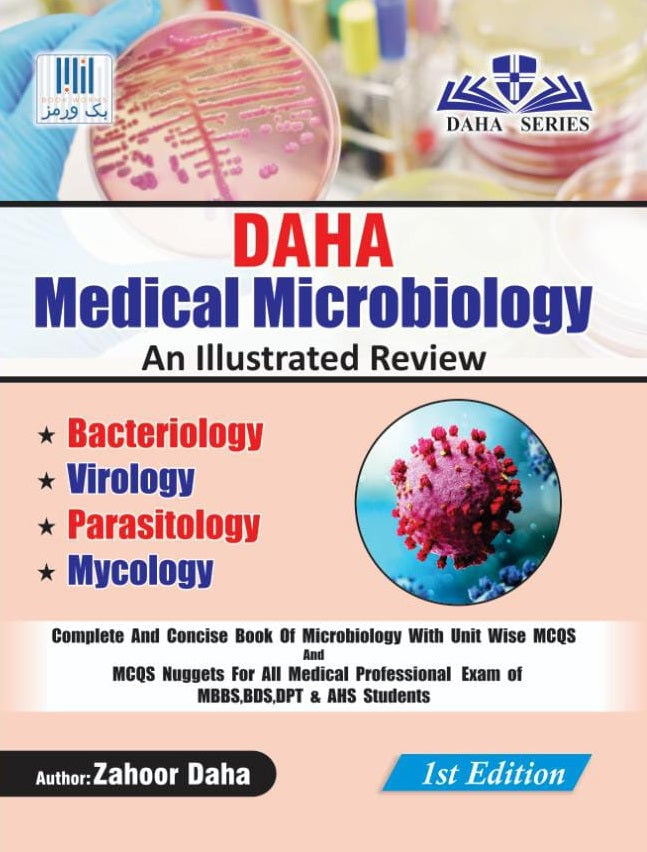

-25%
DAHA MEDICAL MICROBIOLOGY AN ILLUSTRATED REVIEW
8 sold in last 12 hours
Regular price
Rs.625
Sale price
Rs.835
people are viewing this right now
Hurry Up! Only 50 left in stock!
Couldn't load pickup availability
Estimate delivery times: 01 - 03 days (Major Cities Pakistan )
Return within 05 days of purchase. Duties & taxes are non-refundable.